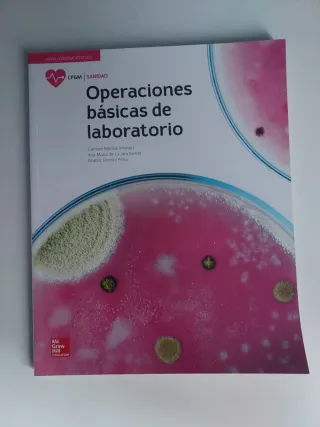

Libros Grado Medio de segunda mano Bilbao
Novedades
Matemáticas. Graduado en educación secundaria (...
Libro nuevo, perteneciente a la prueba de acceso para grado medio de la editorial MAD. Más libros nuevos en mi perfil, pregunta sin compromiso.
FOL GRADO MEDIO SERIE ACTIVA
Libro nuevo, perteneciente al grado medio de la editorial Santillana. Más libros nuevos en mi perfil, pregunta sin compromiso.
Empresa e iniciativa emprendedora. Grado medio/...
Libro nuevo, perteneciente al modulo transversal de la editorial Mcgrawhill. Más libros nuevos en mi perfil, pregunta sin compromiso.
OFFICE ADMINISTRATION WB Grado Medio ED.13 Burl...
Student's Book Y Workbook Buen estado y con algún ejercicio escrito a lapiz
LA+SB Higiene del medio hospitalario. Libro alu...
Libro nuevo, perteneciente al grado medio del área de sanidad de la editorial Mc Graw Hill. Más libros nuevos en mi perfil, pregunta sin compromiso.
#GESTION DE LOS APROVECHAMIENTOS DEL MEDIO FORE...
Libro nuevo, perteneciente al grado superior de la editorial Aran. Más libros nuevos en mi perfil, pregunta sin compromiso.
Técnico superior en gestión forestal y del medi...
Libro nuevo, perteneciente al grado superior de la editorial Aran. Más libros nuevos en mi perfil, pregunta sin compromiso. Último ejemplar disponible.
Operaciones básicas de laboratorio
Libro nuevo, perteneciente al grado medio del área de sanidad de la editorial Mac Graw Hill. Tres unidades disponibles. Más libros nuevos en mi perfil, pregunta sin compromiso.
LA+SB Tecnicas basicas de enfermeria GM. Libro ...
Libro nuevo, perteneciente al grado medio del área de sanidad de la editorial Mc Graw Hill. Más libros nuevos en mi perfil, pregunta sin compromiso.
CUADERNO TEORIA 1 GRADO MEDIO R.MUSIC
En buen estado
Oficina de farmacia
Libro nuevo, perteneciente al grado medio de farmacia y parafarmacia de la editorial Altamar. Más libros nuevos en mi perfil, pregunta sin compromiso.
SIBEMOL - Lenguaje Musical Ritmico 5º (Grado Medio 1º) (Robles Ojeda)
En buen estado
LA - Tecnica contable GM. Libro alumno.
Libro nuevo, perteneciente al grado medio de administración de la editorial Mac Graw Hill. Más libros nuevos en mi perfil, pregunta sin compromiso.
Higiene del medio hospitalario y limpiea de
Libro nuevo, perteneciente al grado medio del área de sanidad de la editorial Mac Graw Hill. Tiene el lomo un pelin marcado, pero el libro es completamente nuevo. Más libros nuevos en mi perfil, pregunta sin compromiso.
Higiene en el medio hospitalario
Texto: Grado Auxiliar Enfermería.
Dispensación de productos parafarmacéuticos
Libro nuevo, perteneciente al grado medio de farmacia y parafarmacia de la editorial Altamar. Más libros nuevos en mi perfil, pregunta sin compromiso.

Técnicas básicas de enfermería
Libro grado medio
Planes de emergencia y dispositivos de riesgos ...
Libro nuevo, perteneciente al grado medio de atención sanitaria de la editorial Altamar. Más libros nuevos en mi perfil, pregunta sin compromiso.
Técnicas de ayuda odontológica y estomatológica
Libro nuevo, perteneciente al grado medio del área de sanidad de la editorial Mc Graw Hill. Más libros nuevos en mi perfil, pregunta sin compromiso.
Libro formación y orientación laboral
Libro de orientación y formación laboral grado superior y medio
Libro auxiliar enfermería
Libro para el grado medio de TCAE, subrayado pero muy muy cuidado.
Operaciones administrativas de compraventa
Libro nuevo, perteneciente al grado medio de administración y gestion de la editorial Santillana, incluye DVD. Más libros nuevos en mi perfil, pregunta sin compromiso.
Comunicación empresarial y atención al cliente
Libro nuevo, perteneciente al grado medio de administración y gestion de la editorial Santillana, contiene DVD. Más libros nuevos en mi perfil, pregunta sin compromiso.
TECNICA CONTABLE, GESTION ADMINISTRATIVA GM
Libro nuevo, perteneciente al grado medio de administración y gestion de la editorial Santillana, contiene DVD. Más libros nuevos en mi perfil, pregunta sin compromiso.
Promoción de la salud y apoyo psicológico al pa...
Libro nuevo, perteneciente al grado medio del área de sanidad de la editorial Mc Graw Hill. Más libros nuevos en mi perfil, pregunta sin compromiso.
Operaciones administrativas y documentación san...
Libro nuevo, perteneciente al grado medio del área de sanidad de la editorial Mc Graw Hill. Más libros nuevos en mi perfil, pregunta sin compromiso.
Investigación comercial
Libro nuevo, perteneciente al grado medio de comercio marketing de la editorial Paraninfo. Más libros nuevos en mi perfil, pregunta sin compromiso. Último ejemplar disponible.
Financiación internacional: Rústica
Libro nuevo, perteneciente al grado medio de comercio marketing de la editorial Paraninfo. Más libros nuevos en mi perfil, pregunta sin compromiso. Último ejemplar disponible.
Comercio digital internacional
Libro nuevo, perteneciente al grado medio de comercio marketing de la editorial Paraninfo. Más libros nuevos en mi perfil, pregunta sin compromiso.
LA Promocion de la salud (Spanish Edition)
Libro nuevo, perteneciente al grado medio del área de sanidad de la editorial Mac Graw Hill. Más libros nuevos en mi perfil, pregunta sin compromiso.
Operaciones básicas de laboratorio
Libro nuevo, perteneciente al grado medio de farmacia y parafarmacia de la editorial Altamar. Más libros nuevos en mi perfil, pregunta sin compromiso.
Gestión administrativa del comercio internacional
Libro nuevo, perteneciente al grado medio de comercio marketing de la editorial Paraninfo. Más libros nuevos en mi perfil, pregunta sin compromiso.
Matemáticas. Graduado en educación secundaria (...
Libro nuevo, perteneciente a la prueba de acceso para grado medio de la editorial MAD. Más libros nuevos en mi perfil, pregunta sin compromiso.
Dispensación de productos
Libro nuevo, perteneciente al grado medio del área de sanidad de la editorial Mc Graw Hill. Más libros nuevos en mi perfil, pregunta sin compromiso.
Anatomofisiología y patología básicas
Libro nuevo, perteneciente al grado medio del área de sanidad de la editorial Mc Graw Hill. Más libros nuevos en mi perfil, pregunta sin compromiso.
Montaje y mantenimiento de equipo
Libro nuevo, perteneciente al grado medio de sistemas microinformáticos y redes de la editorial Síntesis. Más libros nuevos en mi perfil, pregunta sin compromiso.
Disposición y venta de productos
Libro nuevo, perteneciente al grado medio del área de sanidad de la editorial Mc Graw Hill. Más libros nuevos en mi perfil, pregunta sin compromiso.
Aplicaciones ofimaticas
Libro nuevo, perteneciente al grado medio de la editorial Mc Graw Hill. Más libros nuevos en mi perfil, pregunta sin compromiso.
Oficina de farmacia
Libro nuevo, perteneciente al grado medio del área de sanidad de la editorial Mc Graw Hill. Más libros nuevos en mi perfil, pregunta sin compromiso.
Sistemas operativos monopuesto
Libro nuevo, perteneciente al grado medio de la editorial Mc Graw Hill. Más libros nuevos en mi perfil, pregunta sin compromiso.
Sistemas operativos en red
Libro nuevo, perteneciente al grado medio de la editorial Mc Graw Hill. Más libros nuevos en mi perfil, pregunta sin compromiso.
Infraestructuras comunes de telecomunicación
Libro nuevo, perteneciente al grado medio de la editorial MC Graw Hill. Más libros nuevos en mi perfil, pregunta sin compromiso.
Instalaciones solares fotovoltaicas
Libro nuevo, perteneciente al grado medio de electricidad de la editorial Mc Graw Hill. Más libros nuevos en mi perfil, pregunta sin compromiso.
Gestión de compras
Libro nuevo, perteneciente al grado medio de comercio y marketing de la editorial Mc Graw Hill. Más libros nuevos en mi perfil, pregunta sin compromiso.
Procesos de venta
Libro nuevo, perteneciente al grado medio de comercio y marketing de la editorial Mc Graw Hill. Más libros nuevos en mi perfil, pregunta sin compromiso.
Dinamización del punto de venta
Libro nuevo, perteneciente al grado medio de comercio y marketing de la editorial Mc Graw Hill. Más libros nuevos en mi perfil, pregunta sin compromiso.
Aplicaciones informáticas para el comercio
Libro nuevo, perteneciente al grado medio de la editorial Mc Graw Hill. Más libros nuevos en mi perfil, pregunta sin compromiso.
Relaciones en el equipo de trabajo
Libro nuevo, perteneciente al grado medio de la editorial Mac Graw Hill. Más libros nuevos en mi perfil, pregunta sin compromiso.
Empresa y administración
Libro usado para consultas, perteneciente al grado medio de administración de la editorial Mac Graw Hill. Más libros nuevos en mi perfil, pregunta sin compromiso.
Empresa y administración
Libro nuevo, perteneciente al grado medio de administración de la editorial Mc Graw Hill. Más libros nuevos en mi perfil, pregunta sin compromiso.
Técnica contable
Libro nuevo, perteneciente al grado medio de administración de la editorial Mc Graw Hill. Más libros nuevos en mi perfil, pregunta sin compromiso.
Comunicación empresarial y atención al cliente
Libro nuevo, perteneciente al grado medio de administración de la editorial Mc Graw Hill. Más libros nuevos en mi perfil, pregunta sin compromiso.
Relaciones en el equipo de trabajo
Libro nuevo, perteneciente al grado medio de la editorial Mc Graw Hill. Más libros nuevos en mi perfil, pregunta sin compromiso.
Formulación magistral
Libro nuevo, perteneciente al grado medio del área de sanidad de la editorial Mc Graw Hill. Más libros nuevos en mi perfil, pregunta sin compromiso.

Temario Titulado Grado Medio en Formación y Empleo
Temario Oposición Titulado/a de Grado Medio en Formación y Empleo Navarra (convocatoria 2025). 37 plazas. Apuntes academia.
Postres en restauracion
Libro de módulo transversal de FP grado medio de cocina. Módulo de postres en restauracion
Relaciones en el equipo del trabajo. Grado Medio
Relaciones en el equipo de trabajo

Promoción de la salud y apoyo psicológico al pa...
Libro Promoción de la Salud y Apoyo Psicológico al Paciente en estado totalmente nuevo, sin uso. Perfecto para estudiantes de FP Grado Medio y Grado Superior en Sanidad. Páginas limpias, sin marcas, sin apuntes ni dobleces. Ideal para preparar módulos de promoción de la salud y apoyo emocional al paciente.
Encuentra lo que buscas en Wallapop:
También puede interesarte
Libros Grado Medio peluquería
Libros Grado Medio Auxiliar farmacia
Libros Grado Medio informática
Libros Grado Medio automoción
Libros Disney
Libros Uned
Libros Don Quijote de la Mancha
Libros Harry Potter
Libros infantiles
Libros diario de Greg
Libros inglés
Libros Geronimo Stilton
Libros religiosos
Libros juego de tronos
Libros El Lazarillo de Tormes
Libros de autoayuda